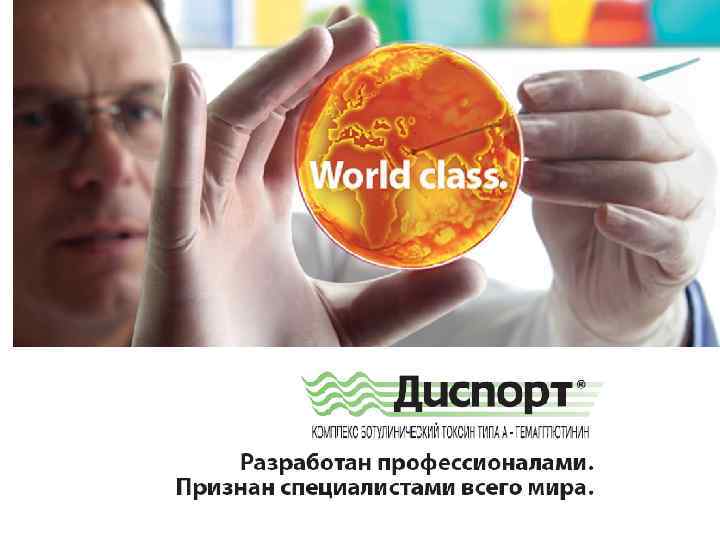

ДЦП у взрослых -антипенко.ppt
- Количество слайдов: 30
 ДЦП у взрослых VII межрегиональная научно-практическая конференция «Актуальные вопросы практической неврологии и психиатрии» 19 -20 октября 2016 года Нижний Новгород доцент кафедры неврологии, психиатрии и наркологии ФПКВ ГБОУ ВО Ниж. ГМА МЗ РФ д. м. н. Антипенко Е. А.
ДЦП у взрослых VII межрегиональная научно-практическая конференция «Актуальные вопросы практической неврологии и психиатрии» 19 -20 октября 2016 года Нижний Новгород доцент кафедры неврологии, психиатрии и наркологии ФПКВ ГБОУ ВО Ниж. ГМА МЗ РФ д. м. н. Антипенко Е. А.
 Детский церебральный паралич – непрогрессирующие моторные и психоречевые нарушения, являющиеся результатом поражения центральной нервной системы в пре и перинатальном периоде Это неизлечимое заболевание ДЕТСКИЙ? ЦЕРЕБРАЛЬНЫЙ? ПАРАЛИЧ?
Детский церебральный паралич – непрогрессирующие моторные и психоречевые нарушения, являющиеся результатом поражения центральной нервной системы в пре и перинатальном периоде Это неизлечимое заболевание ДЕТСКИЙ? ЦЕРЕБРАЛЬНЫЙ? ПАРАЛИЧ?
 Реабилитация при ДЦП 0 -2 года - стимуляционные методики 2 - 5 лет - борьба с патологически высоким мышечным тонусом 5 -10 лет - коррекция сформированного патологического паттерна движения Коррекция динамичных и фиксированных контрактур 10 и более -? ? А после 18 - ? ? !!!
Реабилитация при ДЦП 0 -2 года - стимуляционные методики 2 - 5 лет - борьба с патологически высоким мышечным тонусом 5 -10 лет - коррекция сформированного патологического паттерна движения Коррекция динамичных и фиксированных контрактур 10 и более -? ? А после 18 - ? ? !!!
 Собственные наблюдения 42 пациента с диагнозом ДЦП (I-III уровни по GMFCS). • 20 подростков 14 -18 лет (11 м. , 9 д. ) 12 - спастическая диплегия (G 80. 1) 3 - двойная гемиплегическая форма ДЦП (G 80. 0) 3 - гемипаретическая форма (G 80. 2) 2 - гиперкинетический вариант ДЦП • 22 взрослых 19 -34 лет (12 м. , 10 ж. ): 19 - спастическая диплегия (G 80. 1) 3 - гемипаретическая форма (G 80. 2) У всех обследованных пациентов ранее были сформированы основные двигательные навыки, в том числе ходьба
Собственные наблюдения 42 пациента с диагнозом ДЦП (I-III уровни по GMFCS). • 20 подростков 14 -18 лет (11 м. , 9 д. ) 12 - спастическая диплегия (G 80. 1) 3 - двойная гемиплегическая форма ДЦП (G 80. 0) 3 - гемипаретическая форма (G 80. 2) 2 - гиперкинетический вариант ДЦП • 22 взрослых 19 -34 лет (12 м. , 10 ж. ): 19 - спастическая диплегия (G 80. 1) 3 - гемипаретическая форма (G 80. 2) У всех обследованных пациентов ранее были сформированы основные двигательные навыки, в том числе ходьба
 • Все пациенты ранее • НО после 10 – 12 лет получали регулярные встал вопрос о курсы реабилитации с целесообразности применением продолжения ботулинотерапии из-за «недостаточной • Эффект удовлетворял пациентов и родителей эффективности» Прогрессирование? Псевдопрогрессирование? Патоморфоз? Патокинез? Изменение ходьбы по сравнению с исходным
• Все пациенты ранее • НО после 10 – 12 лет получали регулярные встал вопрос о курсы реабилитации с целесообразности применением продолжения ботулинотерапии из-за «недостаточной • Эффект удовлетворял пациентов и родителей эффективности» Прогрессирование? Псевдопрогрессирование? Патоморфоз? Патокинез? Изменение ходьбы по сравнению с исходным
 Что мешает реабилитации по мере взросления? • Феномен псевдопрогрессирования • Возрастной патоморфоз заболевания • Множественность неврологических синдромов
Что мешает реабилитации по мере взросления? • Феномен псевдопрогрессирования • Возрастной патоморфоз заболевания • Множественность неврологических синдромов
 Структура двигательного дефекта Спастические синдромы аддукторный спазм rectus-синдром спастичность сгибателей кисти и пальцев выражены умеренно. Снижение мышечной силы незначительно
Структура двигательного дефекта Спастические синдромы аддукторный спазм rectus-синдром спастичность сгибателей кисти и пальцев выражены умеренно. Снижение мышечной силы незначительно
 Выраженность дистонических феноменов Частота встречаемости различных вариантов дистонии % Шкала оценки дистонии Барри-Олбрайт Дистонические феномены выявлены у всех пациентов
Выраженность дистонических феноменов Частота встречаемости различных вариантов дистонии % Шкала оценки дистонии Барри-Олбрайт Дистонические феномены выявлены у всех пациентов
 Использование приобретенных ранее навыков затруднено из-за выраженных дистонических феноменов на фоне умеренно выраженной спастичности Видео демонстрация
Использование приобретенных ранее навыков затруднено из-за выраженных дистонических феноменов на фоне умеренно выраженной спастичности Видео демонстрация
 После курса реабилитации+ ботулинотерапии • Восстановление самостоятельной ходьбы -25 пациентов • Увеличение скорости ходьбы – 11 пациентов • Повышение повседневной активности по индексу Бартел – на 18 баллов • Оценка эффективности лечения пациентом/родителями: • Высокая – у 33 • Умеренная –у 5 • Низкая - у 4
После курса реабилитации+ ботулинотерапии • Восстановление самостоятельной ходьбы -25 пациентов • Увеличение скорости ходьбы – 11 пациентов • Повышение повседневной активности по индексу Бартел – на 18 баллов • Оценка эффективности лечения пациентом/родителями: • Высокая – у 33 • Умеренная –у 5 • Низкая - у 4
 Нет специально разработанных методик и схем при взрослом ДЦП • • • Реабилитация направлена на коррекцию синдромом: Спастический парез Периферический парез Дистонические синдромы Координаторные нарушения Атактические нарушения Нарушения ходьбы и т. д.
Нет специально разработанных методик и схем при взрослом ДЦП • • • Реабилитация направлена на коррекцию синдромом: Спастический парез Периферический парез Дистонические синдромы Координаторные нарушения Атактические нарушения Нарушения ходьбы и т. д.
 Коррекция спастических синдромов • Лечение положением и кинезиотерапия • Физиотерапевтические методы: электростимуляция, тепловые процедуры, криотерапия, ИРТ, массаж • Хирургическое лечение (DBS, ITB) • Медикаментозная терапия: * миорелаксанты преимущественно центрального уровня действия(толперизон, мемантин) * миорелаксанты цереброспинального уровня (бензодиазепины) * миорелаксанты спинального уровня (тизанидин, баклосан, флупиртин) *миорелаксанты синаптического уровня (ботулотоксин)
Коррекция спастических синдромов • Лечение положением и кинезиотерапия • Физиотерапевтические методы: электростимуляция, тепловые процедуры, криотерапия, ИРТ, массаж • Хирургическое лечение (DBS, ITB) • Медикаментозная терапия: * миорелаксанты преимущественно центрального уровня действия(толперизон, мемантин) * миорелаксанты цереброспинального уровня (бензодиазепины) * миорелаксанты спинального уровня (тизанидин, баклосан, флупиртин) *миорелаксанты синаптического уровня (ботулотоксин)
 Механизм действия Баклофена Порочный круг Активация ГАМК-брецепторов приводит к уменьшению выделения возбуждающих аминокислот (глутамат и аспартат) Агонист GABABрецепторов ГАМКгаммааминомасляная кислоты – медиатор торможения GABAB БАКЛОФЕН Постсинаптическая мем Рецептор возбудительного нерва
Механизм действия Баклофена Порочный круг Активация ГАМК-брецепторов приводит к уменьшению выделения возбуждающих аминокислот (глутамат и аспартат) Агонист GABABрецепторов ГАМКгаммааминомасляная кислоты – медиатор торможения GABAB БАКЛОФЕН Постсинаптическая мем Рецептор возбудительного нерва
 Баклосан Наиболее физиологичный миорелаксант • Задействует естественные механизмы регуляции мышечного тонуса • Активирует естественную антиноцицептивную систему
Баклосан Наиболее физиологичный миорелаксант • Задействует естественные механизмы регуляции мышечного тонуса • Активирует естественную антиноцицептивную систему
 • Дает возможность тонкой подстройки под выраженность болевого синдрома и мышечного спазма Выраженный спазм и боль Умеренный спазм и боль я рна ! ели сть Юв чно то 30 мг. 10 мг Баклосан 75 мг
• Дает возможность тонкой подстройки под выраженность болевого синдрома и мышечного спазма Выраженный спазм и боль Умеренный спазм и боль я рна ! ели сть Юв чно то 30 мг. 10 мг Баклосан 75 мг
 Механизм действия Флупиртина Флупиртин действует на уровне задних рогов спинного мозга, селективно открывая калиевые каналы нейрона, стабилизируя мембранный потенциал и снижая возбудимости нейронов снижает степень выраженности боли уменьшает мышечный спазм препятствует переходу боли в хроническую способствует «стиранию» болевой памяти
Механизм действия Флупиртина Флупиртин действует на уровне задних рогов спинного мозга, селективно открывая калиевые каналы нейрона, стабилизируя мембранный потенциал и снижая возбудимости нейронов снижает степень выраженности боли уменьшает мышечный спазм препятствует переходу боли в хроническую способствует «стиранию» болевой памяти
 Нолодатак® (Флупиритина мале q Селективный активатор нейрональных калиевых каналов - SNEPCO ( «Selective Neuronal Potassiu q Неопиоидный анальгетик центрального действия Не влияет на нормальный мышечный тонус Не обладает ульцерогенным действием Может применяться более длительно, чем НПВП Не вызывает привыкания и зависимости Обезболивающее действие Миорелаксирующее действие Нейропротективное действие «Стира предот
Нолодатак® (Флупиритина мале q Селективный активатор нейрональных калиевых каналов - SNEPCO ( «Selective Neuronal Potassiu q Неопиоидный анальгетик центрального действия Не влияет на нормальный мышечный тонус Не обладает ульцерогенным действием Может применяться более длительно, чем НПВП Не вызывает привыкания и зависимости Обезболивающее действие Миорелаксирующее действие Нейропротективное действие «Стира предот
 • Ботулинотерапия – эффективный и безопасный метод лечения спастичности • Ботокс - Аллерган, США. Хранение в морозильнике или в холодильнике • Диспорт – Ипсен, Франция Хранение +2+8 град. (холодильник) • Лантокс – Ланчжоусский институт биологической продукции, Китай Хранение в морозильнике • Ксеомин – Мерц, Германия Хранится при комнатной темп. Очищен от нетоксиновых белков! Релатокс –Микроген, Россия
• Ботулинотерапия – эффективный и безопасный метод лечения спастичности • Ботокс - Аллерган, США. Хранение в морозильнике или в холодильнике • Диспорт – Ипсен, Франция Хранение +2+8 град. (холодильник) • Лантокс – Ланчжоусский институт биологической продукции, Китай Хранение в морозильнике • Ксеомин – Мерц, Германия Хранится при комнатной темп. Очищен от нетоксиновых белков! Релатокс –Микроген, Россия
Диспорт Форма выпуска Комплекс ботулинический токсин типа А: Гемагглютинин - 500 ЕД Альбумин - 125 мкг Лактоза - 2, 5 мг Лиофилизированный порошок Диспорта ® разводится в 0, 9% растворе хлорида натрия для инъекций в соотношении от 1 до 2, 5 мл р-ра на 1 флакон Диспорта ® в зависимости от показаний ®
Диспорт Форма выпуска Комплекс ботулинический токсин типа А: Гемагглютинин - 500 ЕД Альбумин - 125 мкг Лактоза - 2, 5 мг Лиофилизированный порошок Диспорта ® разводится в 0, 9% растворе хлорида натрия для инъекций в соотношении от 1 до 2, 5 мл р-ра на 1 флакон Диспорта ® в зависимости от показаний ®
 Среднее значение мышечного тонуса по MAS в популяции пациентов, получающих терапию Абоботулотоксином типа А Применение препарата Диспорт® в обоих дозах 500 ЕД и 1000 ЕД приводит к клинически значимому снижению мышечного тонуса по MAS уже на 1 неделе терапии с сохранением эффекта до 20 недели 1 1. v Среднее снижение мышечного тонуса по MAS на 1 недели: -0. 2 плацебо, -0. 7 Диспорт® 500 ЕД, and -0. 9 Диспорт® 1, 000 ЕД v Улучшение по шкале MAS применении препарата Диспорт® в группе сравнения с плацебо сохранялось до 20 недели Недели Jean-Michel Gracies et al. Safety and effi cacy of abobotulinumtoxin. A for hemiparesis in adults with upper limb spasticity after stroke or traumatic brain injury: a double-blind randomised controlled trial, Lancet Neurol 2015, http: //dx. doi. org/10. 1016/S 1474 -4422(15)00216 -1
Среднее значение мышечного тонуса по MAS в популяции пациентов, получающих терапию Абоботулотоксином типа А Применение препарата Диспорт® в обоих дозах 500 ЕД и 1000 ЕД приводит к клинически значимому снижению мышечного тонуса по MAS уже на 1 неделе терапии с сохранением эффекта до 20 недели 1 1. v Среднее снижение мышечного тонуса по MAS на 1 недели: -0. 2 плацебо, -0. 7 Диспорт® 500 ЕД, and -0. 9 Диспорт® 1, 000 ЕД v Улучшение по шкале MAS применении препарата Диспорт® в группе сравнения с плацебо сохранялось до 20 недели Недели Jean-Michel Gracies et al. Safety and effi cacy of abobotulinumtoxin. A for hemiparesis in adults with upper limb spasticity after stroke or traumatic brain injury: a double-blind randomised controlled trial, Lancet Neurol 2015, http: //dx. doi. org/10. 1016/S 1474 -4422(15)00216 -1
 Помимо снижения мышечного тонуса инъекции препарата Диспорт® приводят к клинически значимому количественному снижению истинной спастичности по шкале Тардье 1 Уменьшение угла спастичности по шале Тардье на 4 -й неделе после инъекции Среднее значение по сравнению с исходным уровнем В сгибателях локтя в сгибателях пальцев в сгибателях запястья 1. Jean-Michel Gracies et al. Safety and effi cacy of abobotulinumtoxin. A for hemiparesis in adults with upper limb spasticity after stroke or traumatic brain injury: a double-blind randomised controlled trial, Lancet Neurol 2015, http: //dx. doi. org/10. 1016/S 1474 -4422(15)00216 -1
Помимо снижения мышечного тонуса инъекции препарата Диспорт® приводят к клинически значимому количественному снижению истинной спастичности по шкале Тардье 1 Уменьшение угла спастичности по шале Тардье на 4 -й неделе после инъекции Среднее значение по сравнению с исходным уровнем В сгибателях локтя в сгибателях пальцев в сгибателях запястья 1. Jean-Michel Gracies et al. Safety and effi cacy of abobotulinumtoxin. A for hemiparesis in adults with upper limb spasticity after stroke or traumatic brain injury: a double-blind randomised controlled trial, Lancet Neurol 2015, http: //dx. doi. org/10. 1016/S 1474 -4422(15)00216 -1
 Диспорт Показания к применению • • • Блефароспазм Гемифациальный спазм Спастическая кривошея Спастичность руки после инсульта Гиперкинетические складки (мимические морщины) лица у взрослых • Динамическая деформация стопы, вызванная спастичностью, у детей с ДЦП с 2 -летнего возраста • Гипергидроз подмышечной области • Фокальная спастичность! NEW!
Диспорт Показания к применению • • • Блефароспазм Гемифациальный спазм Спастическая кривошея Спастичность руки после инсульта Гиперкинетические складки (мимические морщины) лица у взрослых • Динамическая деформация стопы, вызванная спастичностью, у детей с ДЦП с 2 -летнего возраста • Гипергидроз подмышечной области • Фокальная спастичность! NEW!
 Коррекция дистонических синдромов • • • Атипичные нейролептики Бензодиазепины (клоназепам) Холинолитики Агонисты и антагонисты дофаминовых рецепторов Препараты леводопы ГАМК-ергические препараты Антиконвульсанты Хирургическое лечение Ботулинотерапия
Коррекция дистонических синдромов • • • Атипичные нейролептики Бензодиазепины (клоназепам) Холинолитики Агонисты и антагонисты дофаминовых рецепторов Препараты леводопы ГАМК-ергические препараты Антиконвульсанты Хирургическое лечение Ботулинотерапия
 Доказательная база ботулинотерапии Форма дистонии Ксеомин Ботокс Диспорт Блефароспазм А В В Цервикальная дистония А В А Спастичность А В В
Доказательная база ботулинотерапии Форма дистонии Ксеомин Ботокс Диспорт Блефароспазм А В В Цервикальная дистония А В А Спастичность А В В
 bacterial DNA gene cluster Второе поколение токсинов: Ксеомин® proteins Нейротоксиновый комплекс Первое поколение, например. Botox®, Dysport® или Лантокс® S. K. Sharma et al. / Toxicon 41 (2003) 321– 331
bacterial DNA gene cluster Второе поколение токсинов: Ксеомин® proteins Нейротоксиновый комплекс Первое поколение, например. Botox®, Dysport® или Лантокс® S. K. Sharma et al. / Toxicon 41 (2003) 321– 331
 Ксеомин Показания к применению • Блефароспазм • Идиопатическая цервикальная дистония (спастическая кривошея) преимущественно ротационной формы • Спастичность руки после инсульта • Гиперкинетические складки (мимические морщины) лица
Ксеомин Показания к применению • Блефароспазм • Идиопатическая цервикальная дистония (спастическая кривошея) преимущественно ротационной формы • Спастичность руки после инсульта • Гиперкинетические складки (мимические морщины) лица
 Научно-практический проект «ДЦП у взрослых» кафедра неврологии, психиатрии и наркологии ФПКВ Консультативная помощь Ботулинотерапия Реабилитация Куратор проекта доцент кафедры неврологии, психиатрии и наркологии ФПКВ д. м. н. Антипенко Контактный телефон: +7 9519194196 antipenkoea@gmail. com ключевое слово «ДЦП у взрослых»
Научно-практический проект «ДЦП у взрослых» кафедра неврологии, психиатрии и наркологии ФПКВ Консультативная помощь Ботулинотерапия Реабилитация Куратор проекта доцент кафедры неврологии, психиатрии и наркологии ФПКВ д. м. н. Антипенко Контактный телефон: +7 9519194196 antipenkoea@gmail. com ключевое слово «ДЦП у взрослых»
 Заключение • Детский церебральный паралич – актуальная проблема не только детской, но и взрослой неврологии • С возрастом увеличивается значимость дистонических феноменов в формировании двигательного дефекта • Ботулинотерапия остается важнейшей составляющей реабилитации при ДЦП у взрослых. Однако протокол проведения процедуры должен быть модифицирован • Задача реабилитации при взрослом ДЦП – сохранение и развитие приобретенных в детском возрасте навыков и умений ОНИ ЭТОГО ДОСТОЙНЫ!
Заключение • Детский церебральный паралич – актуальная проблема не только детской, но и взрослой неврологии • С возрастом увеличивается значимость дистонических феноменов в формировании двигательного дефекта • Ботулинотерапия остается важнейшей составляющей реабилитации при ДЦП у взрослых. Однако протокол проведения процедуры должен быть модифицирован • Задача реабилитации при взрослом ДЦП – сохранение и развитие приобретенных в детском возрасте навыков и умений ОНИ ЭТОГО ДОСТОЙНЫ!
 Благодарю за внимание!
Благодарю за внимание!


